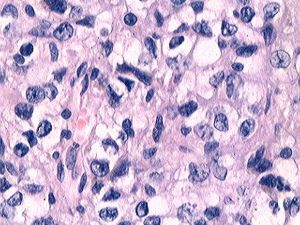
顳葉症狀群

概述
左側顳葉病變
左側顳葉病變顳葉為聽覺言語中樞、聽覺中樞、嗅覺中樞、味覺中樞所在地。顳葉病變時,可出現發作性症候與非發作性症候。
病因病理病機
顱腦外傷、顳葉皮質支及顳葉深動脈閉塞、顳葉腫瘤時,均可導致顳葉損傷,出現相應的臨床症狀。
臨床表現
1.顳葉癲癇:患者表現發作性記憶力障礙,神志恍惚,言語錯亂,精神運動性興奮,情緒和定向力障礙、幻覺、錯覺等。
2.自動症:表現為發作性無意識地自傷、傷人、衝動、毀物等精神運動性興奮,以及不自主地咀嚼,反覆吞咽、口唇亂動、發作性頭眼扭轉,摸索等無目的動作。
3.失語症:Broca氏區及顳葉後部Wernicke氏區與頂葉緣上回的移行區損害時,分別產生運動性失語及感覺性失語。
4.聽覺障礙:雙側顳橫回病變,出現聽覺障礙,表現為皮質性聾。
5.癱瘓:顳葉病變侵犯運動區時,出現對側中樞性面癱或上肢癱,包括面肌在內的偏癱或下肢癱。
6.共濟失調與眩暈:患者表現為軀幹性共濟失調,站立與行走障礙,手指出現指空現象。顳葉彌散性病損,出現主動性眩暈,並常伴有幻覺。
7.視野缺損與眼球震顫:顳葉病變時可出現雙眼對稱或不對稱的視野缺損及出現上1/4象限盲。並常發現有粗大的眼球震顫。
8.眼底與瞳孔的改變:顳葉腫瘤時可出現眼底視乳頭水腫、顳葉癲癇發作、恐怖不安躁動時常有瞳孔變大。
鑑別診斷
(一)顱內腫瘤(intracranialtumor)本病局灶性症狀由於腫瘤部位不同表現不一,中央前、後回的腫瘤,常先出現局限性癲癇發作,並可引起病灶對側肢體的輕癱、單癱、錐體束征,但癱瘓不明顯。
(二)基底動脈血栓形成(basilararterythrombosis)表現眩暈、眼球震顫、共濟失調、四肢癱瘓。共濟失調主要為四肢的共濟運動不協調。癱瘓多經幾小時或1~2天才達高峰。
(三)腦血栓形成(cerebralthrombsis)多於50~60歲發病。一側肢體麻木或無力等前驅症狀往往在安靜狀態或睡眠中起病。病灶位於大腦中動脈的中央支時,表現為偏癱、偏身感覺障礙及面神經和舌下神經的核上性癱。
